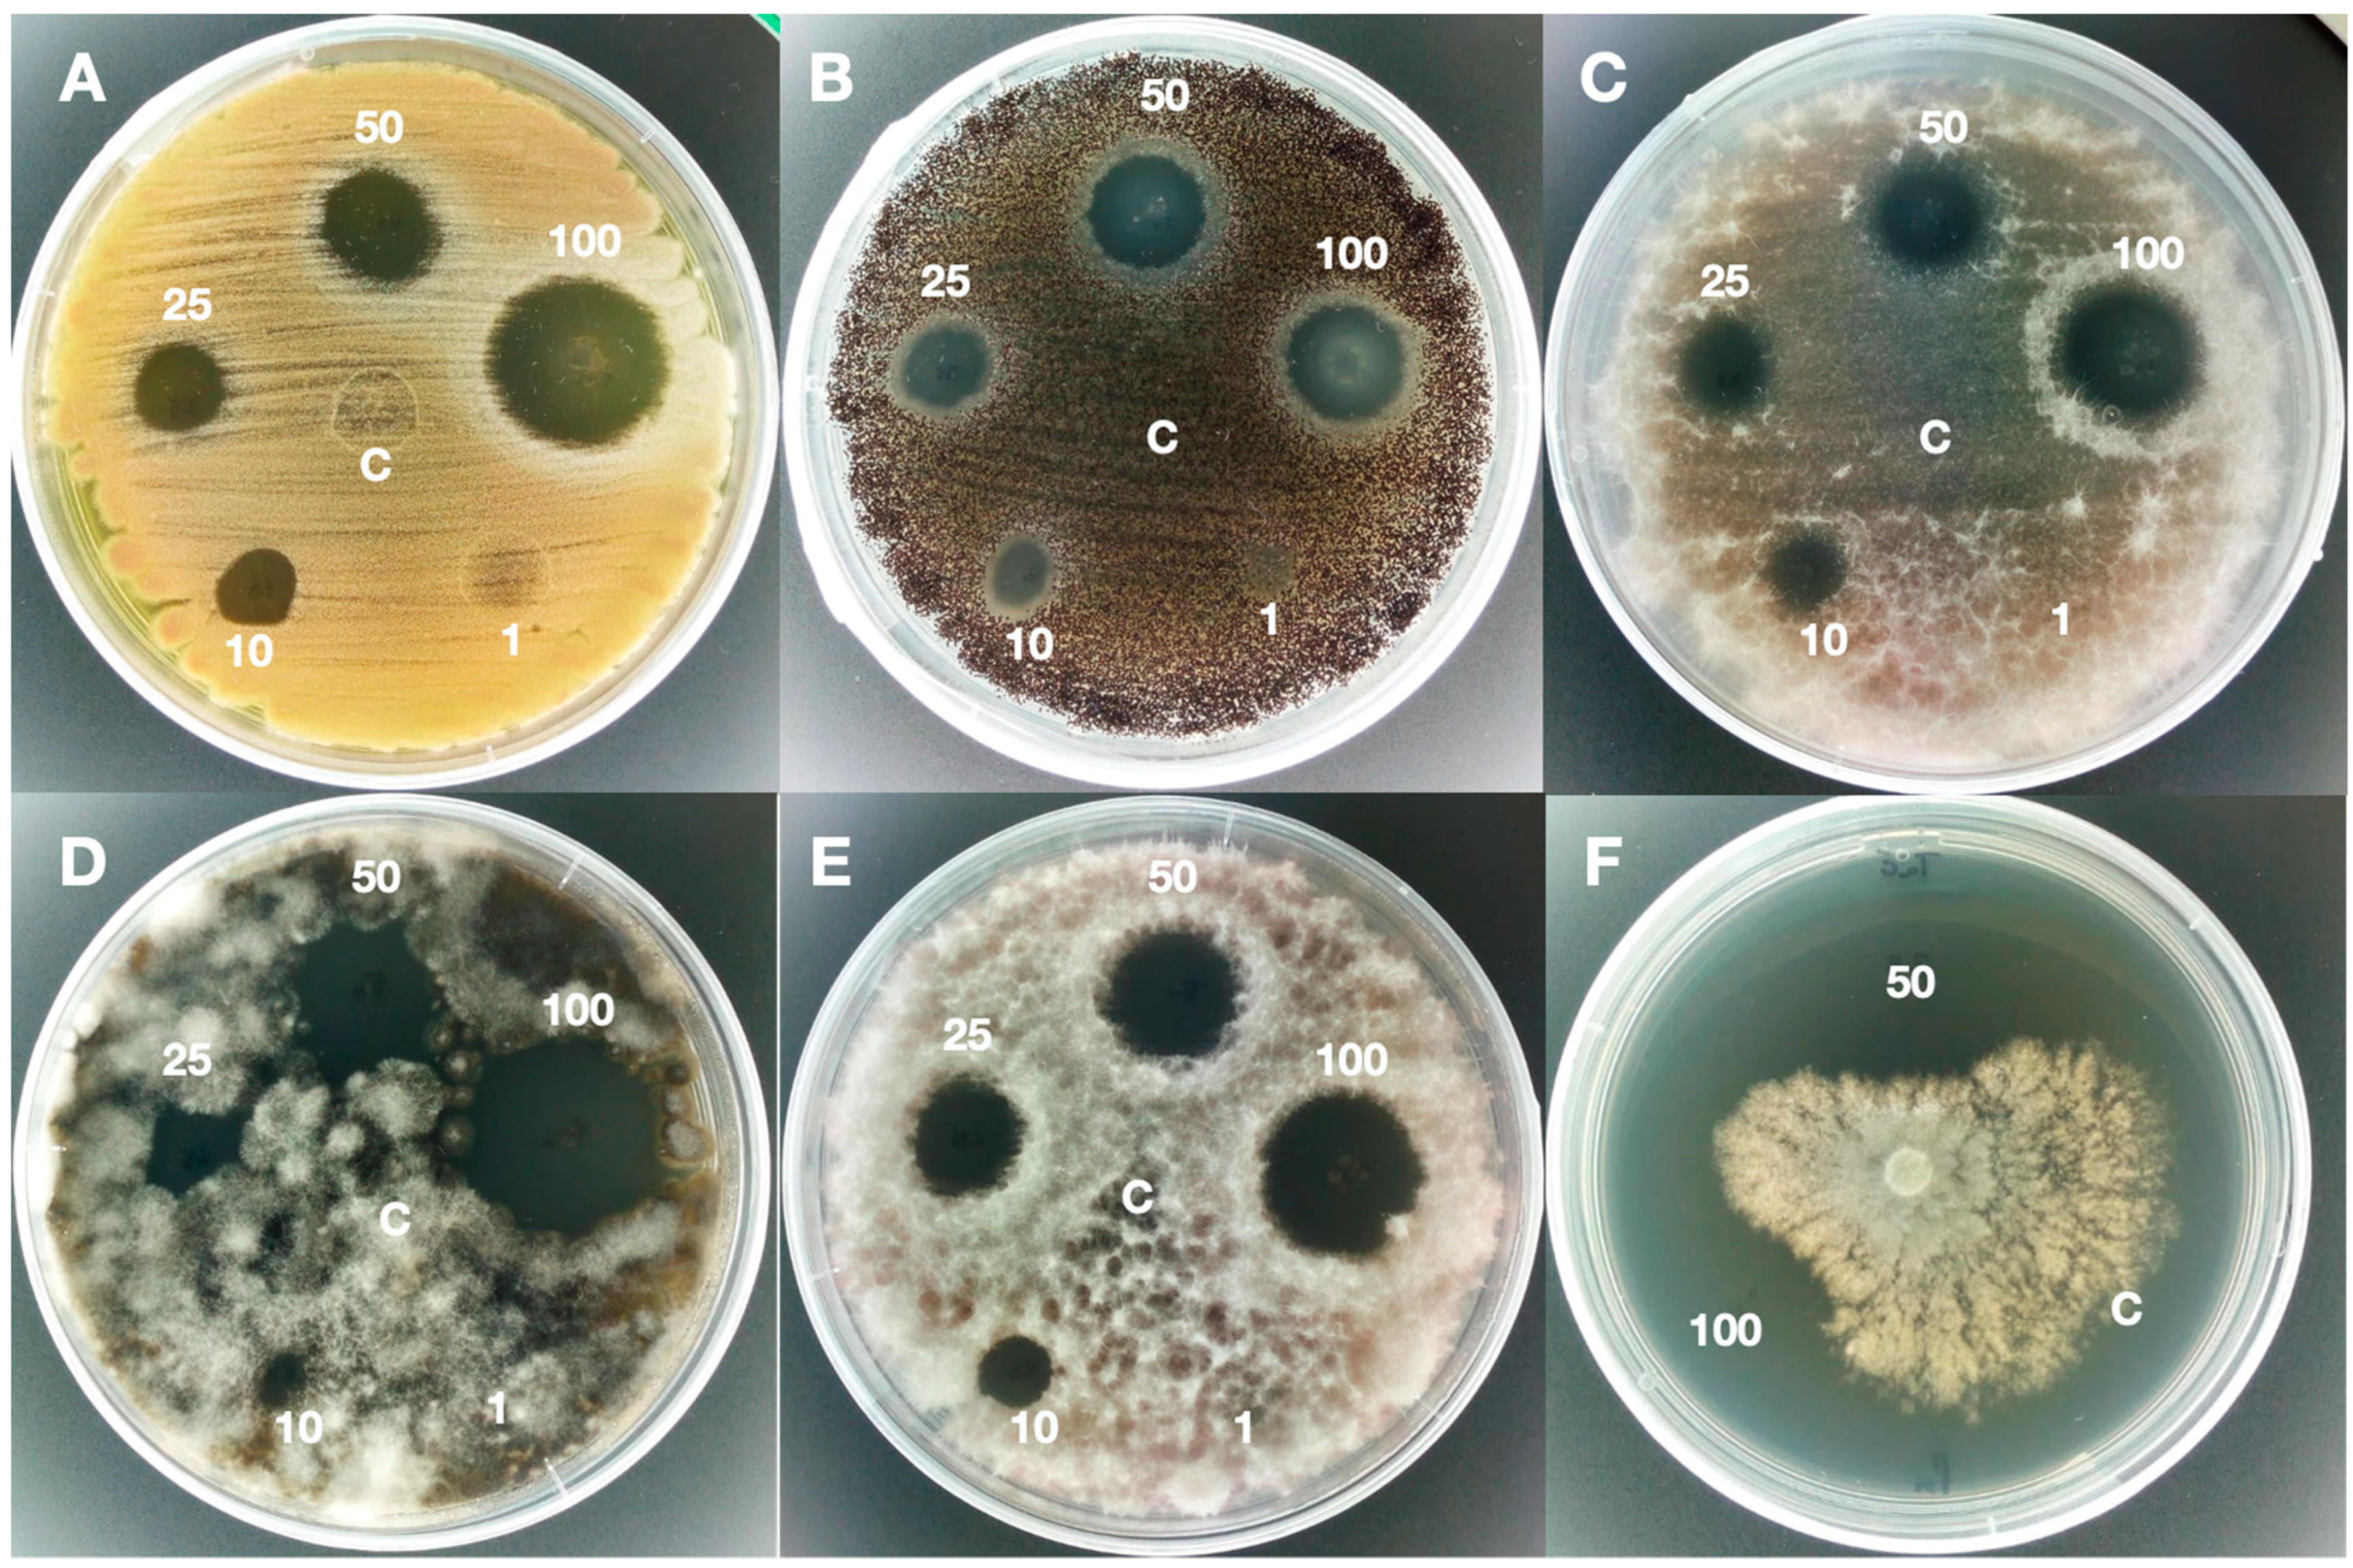
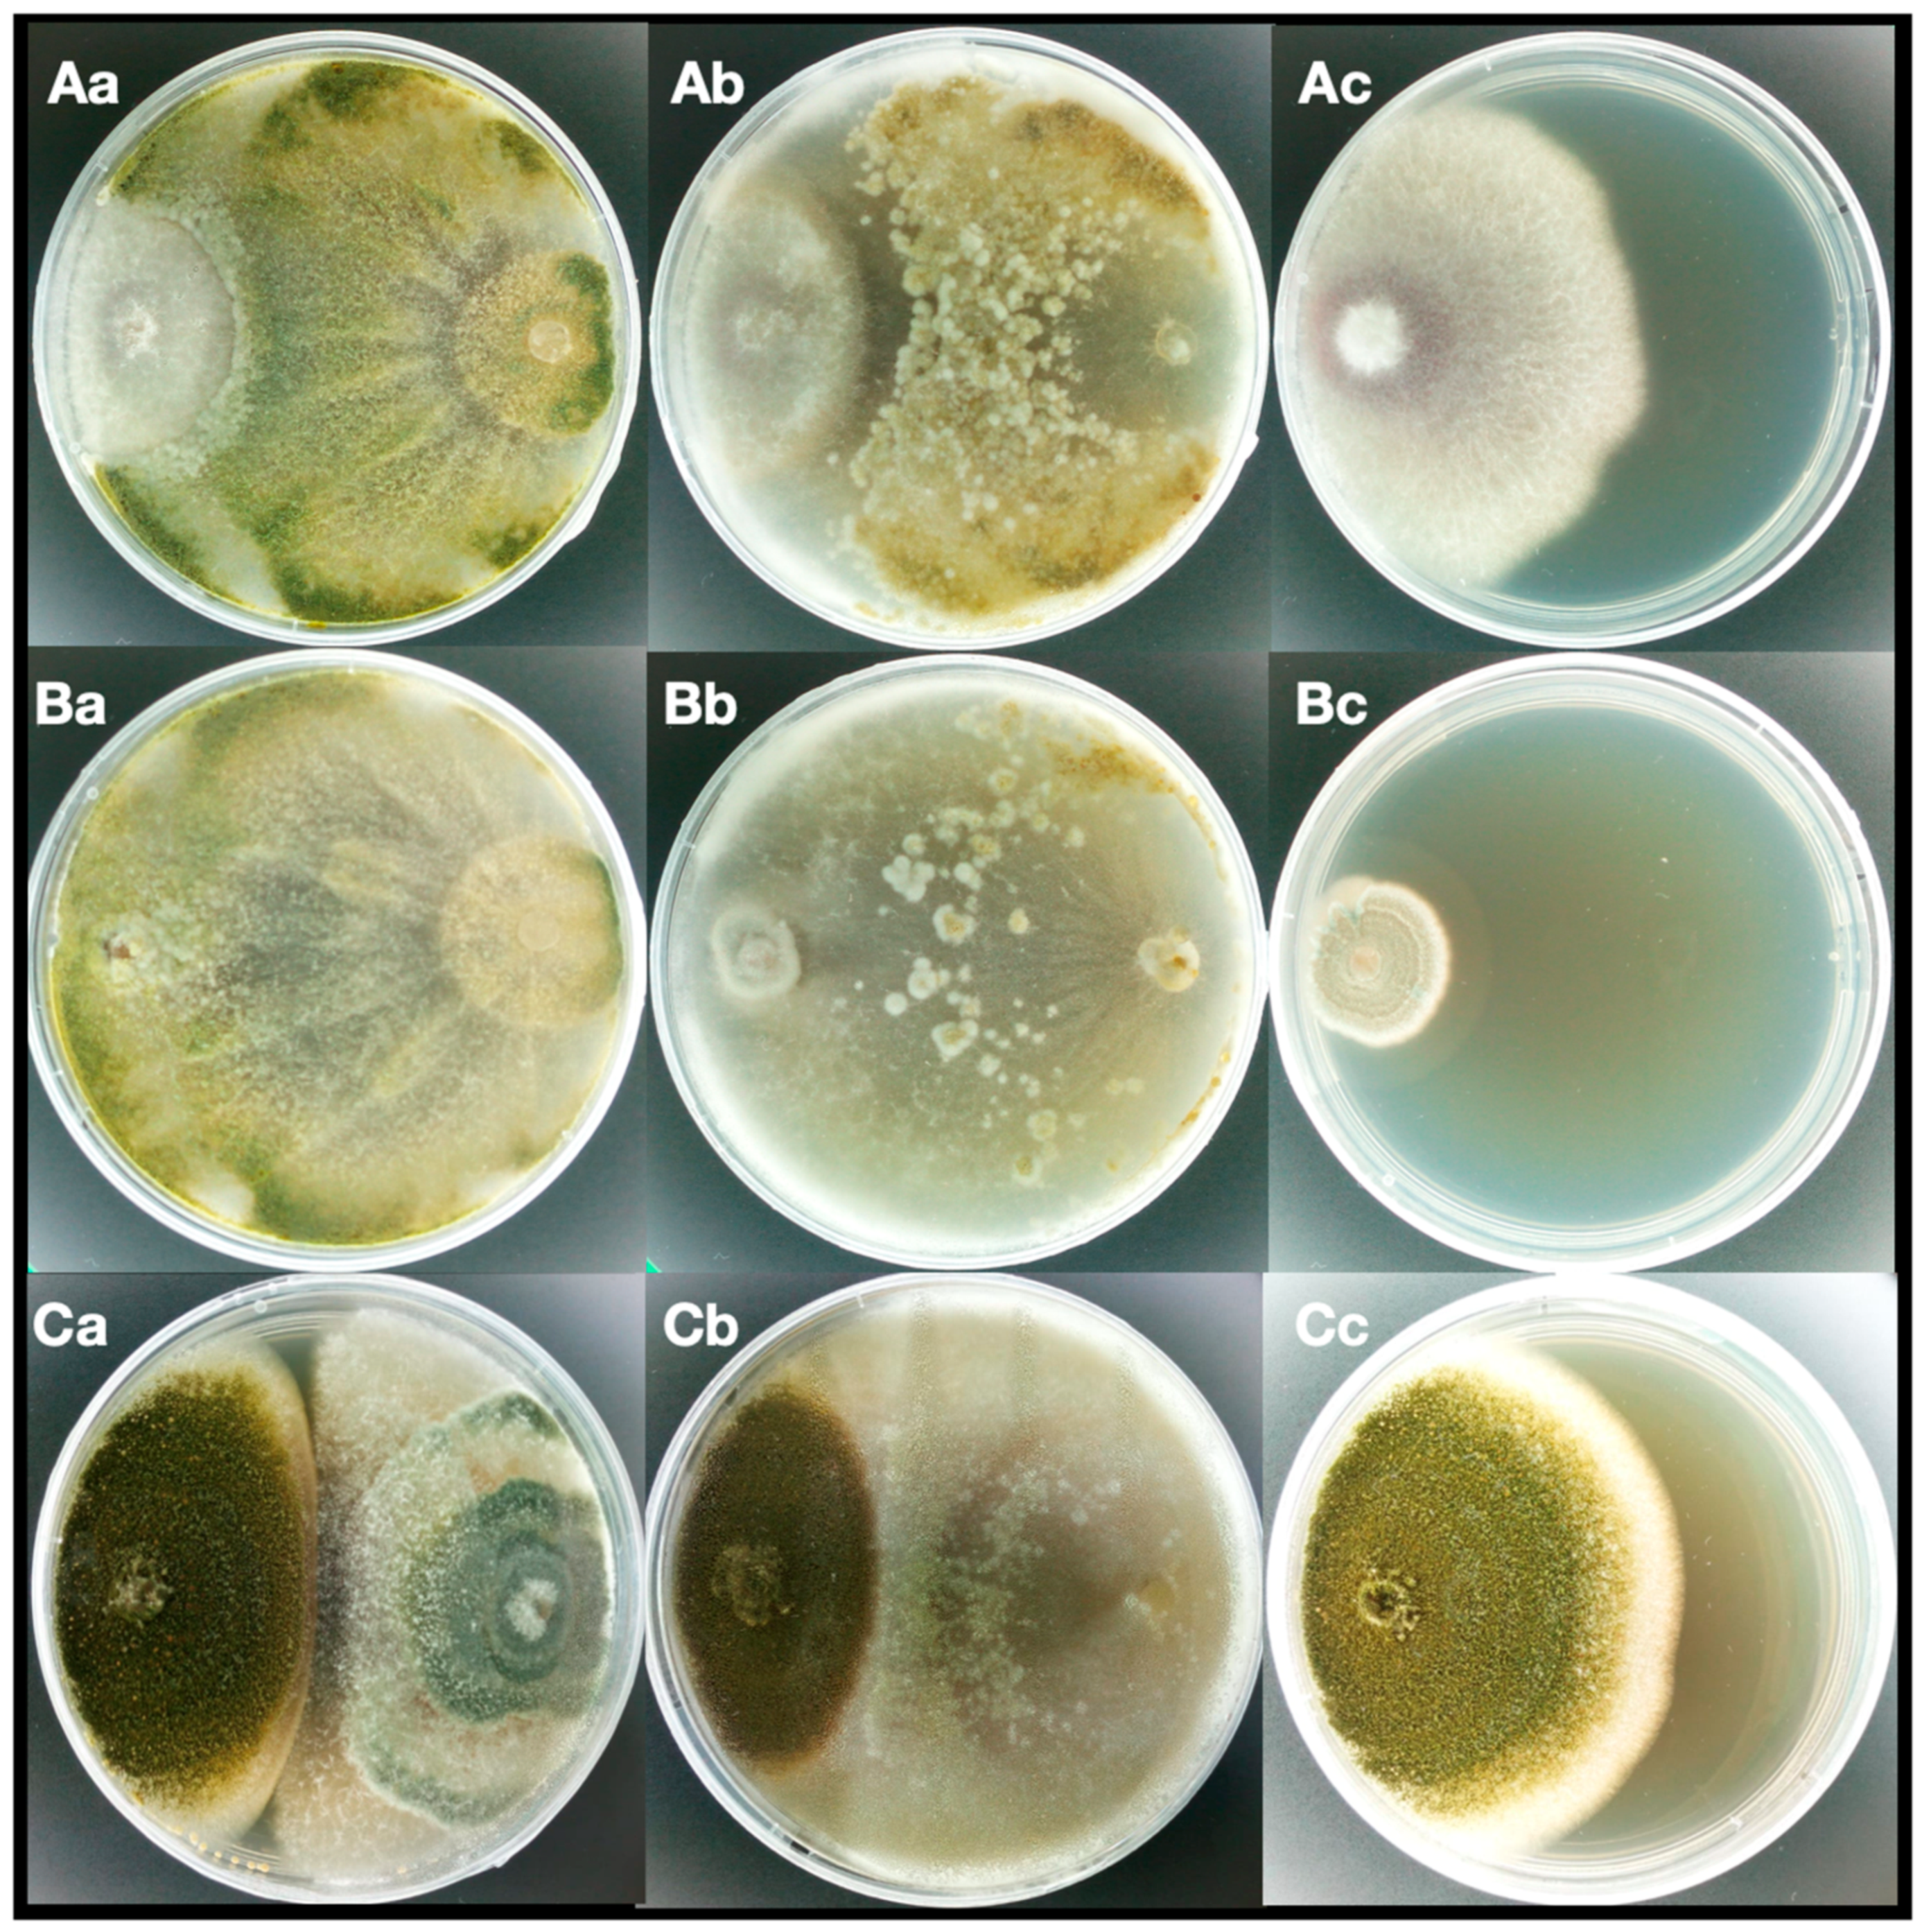

Antifungal Activity of Bioactive Metabolites Produced by Trichoderma asperellum and Trichoderma atroviride in Liquid Medium
Abstract
1. Introduction
2. Materials and Methods
2.1. Chemical Materials
2.2. Fungal Strains, Culture Conditions, and Spore Production
2.3. Isolation and Identification of Trichoderma Strains
2.4. Liquid Culture and Metabolite Production
2.5. Extraction of Metabolites from Liquid Culture
2.6. Agar Diffusion Test
2.7. Antimicrobic Dilution Assay
2.8. Dual Culture Assay
2.9. Analysis of VOCs
2.10. Analysis of nVOCs
3. Results and Discussion
3.1. Antifungal Activity on Solid Medium, MIC, and MFC
3.2. Antagonistic Properties
3.3. Identification of VOCs and nVOCs
4. Conclusions
Author Contributions
Funding
Acknowledgments
Conflicts of Interest
References
- Wightwick, A.; Walters, R.; Allinson, G.; Reichman, S.; Menzies, N. Environmental Risks of Fungicides Used in Horticultural Production Systems. In Fungicides; InTech: Rijeke, Croatria, 2010; pp. 273–304. [Google Scholar]
- Tinker, P.B. The Role of Microorganisms in Mediating and Facilitating the Uptake of Plant Nutrients from Soil. In Biológical Processes and Soil Fertility; Springer: Dordrecht, The Netherlands, 1984; pp. 77–91. [Google Scholar]
- Brent, K.J.; Hollomon, D.W. Fungicide Resistance: The Assessment of Risk, 2nd ed.; FRAC Mongr: Brussels, Belgium, 1998. [Google Scholar]
- Fravel, D.R. Commercialization and Implementation of Biocontrol. Annu. Rev. Phytopathol. 2005, 43, 337–359. [Google Scholar] [CrossRef] [PubMed]
- Harman, G.E.; Howell, C.R.; Viterbo, A.; Chet, I.; Lorito, M. Trichoderma Species—Opportunistic, Avirulent Plant Symbionts. Nat. Rev. Microbiol. 2004, 2, 43–56. [Google Scholar] [CrossRef] [PubMed]
- Köhl, J.; Kolnaar, R.; Ravensberg, W.J. Mode of Action of Microbial Biological Control Agents against Plant Diseases: Relevance beyond Efficacy. Front. Plant Sci. 2019, 10, 845. [Google Scholar] [CrossRef] [PubMed]
- Cardoza, R.-E.; Hermosa, M.-R.; Vizcaíno, J.-A.; Sanz, L.; Monte, E.; Gutiérrez, S. Secondary Metabolites Produced by Trichoderma and Their Importance in the Biocontrol Process. Microorg. Ind. Enzym. Biocontrol 2005, 1, 207–228. [Google Scholar]
- Peñuelas, J.; Asensio, D.; Tholl, D.; Wenke, K.; Rosenkranz, M.; Piechulla, B.; Schnitzler, J.P. Biogenic Volatile Emissions from the Soil. Plant Cell Environ. 2014, 37, 1866–1891. [Google Scholar] [CrossRef]
- Amponsah, N.T.; Jones, E.E.; Ridgway, H.J.; Jaspers, M.V. Production of Botryosphaeria Species Conidia Using Grapevine Green Shoots. N. Z. Plant Prot. 2008, 61, 301–305. [Google Scholar] [CrossRef]
- Nyadanu, D.; Assuah, M.K.; Adomako, B.; Asiama, Y.P.; Opoku, I.Y.; Adu-Ampomah, Y. Efficacy of Screening Methods Used in Breeding for Black Pod Disease Resistance Varieties in Cocoa. Afr. Crop Sci. J. 2009, 17, 175–186. [Google Scholar] [CrossRef]
- Sinclair, J.B.; Dhingra, O.D. Basic Plant Pathology Methods; CRC press: Boca Ratón, FL, USA, 1995. [Google Scholar]
- Cacciola, S.O.; Puglisi, I.; Faedda, R.; Sanzaro, V.; Pane, A.; Piero, A.R.L.; Evoli, M.; Petrone, G. Cadmium Induces Cadmium-Tolerant Gene Expression in the Filamentous Fungus Trichoderma Harzianum. Mol. Biol. Rep. 2015, 42, 1559–1570. [Google Scholar] [CrossRef]
- Puglisi, I.; Faedda, R.; Sanzaro, V.; Piero, A.R.L.; Petrone, G.; Cacciola, S.O. Identification of Differentially Expressed Genes in Response to Mercury I and II Stress in Trichoderma Harzianum. Gene 2012, 506, 325–330. [Google Scholar] [CrossRef]
- White, T.J.; Bruns, T.; Lee, S.; Taylor, J. Amplification and Direct Sequencing of Fungal Ribosomal RNA Genes for Phylogenetics. PCR Protoc. A Guide Methods Appl. 1990, 18, 315–322. [Google Scholar]
- Finch. Available online: https://finchtv.software.informer.com/1.4/ (accessed on 18 May 2019).
- GeneBank. Available online: https://blast.ncbi.nlm.nih.gov/Blast.cgi (accessed on 18 May 2019).
- Petrikkou, E.; Rodriguez-Tudela, J.L.; Cuenca-Estrella, M.; Gomez, A.; Molleja, A.; Mellado, E. Inoculum Standardization for Antifungal Susceptibility Testing of Filamentous Fungi Pathogenic for Humans. J. Clin. Microbiol. 2001, 39, 1345–1347. [Google Scholar] [CrossRef] [PubMed]
- Guarrasi, V.; Sannino, C.; Moschetti, M.; Bonanno, A.; Di Grigoli, A.; Settanni, L. The Individual Contribution of Starter and Non-Starter Lactic Acid Bacteria to the Volatile Organic Compound Composition of Caciocavallo Palermitano Cheese. Int. J. Food Microbiol. 2017, 259, 35–42. [Google Scholar] [CrossRef] [PubMed]
- Denardi-Souza, T.; Luz, C.; Mañes, J.; Badiale-Furlong, E.; Meca, G. Antifungal Effect of Phenolic Extract of Fermented Rice Bran with Rhizopus Oryzae and Its Potential Use in Loaf Bread Shelf Life Extension. J. Sci. Food Agric. 2018, 98, 5011–5018. [Google Scholar] [CrossRef] [PubMed]
- Klich, M.A. Environmental and Developmental Factors Influencing Aflatoxin Production by Aspergillus Flavus and Aspergillus Parasiticus. Mycoscience 2007, 48, 71–80. [Google Scholar] [CrossRef]
- Ibatsam, K.; Rukhsana, B. Prevalence of Post-Harvest Rot of Fruits and Vegetables by Penicillium Species. Int. J. Adv. Res. Biol. Sci 2014, 1, 14–19. [Google Scholar]
- Vinale, F.; Ghisalberti, E.L.; Sivasithamparam, K.; Marra, R.; Ritieni, A.; Ferracane, R.; Woo, S.; Lorito, M. Factors Affecting the Production of Trichoderma Harzianum Secondary Metabolites during the Interaction with Different Plant Pathogens. Lett. Appl. Microbiol. 2009, 48, 705–711. [Google Scholar]
- Fravel, D.R. Role of Antibiosis in the Biocontrol of Plant Diseases. Annu. Rev. Phytopathol. 1988, 26, 75–91. [Google Scholar] [CrossRef]
- John, R.P.; Tyagi, R.D.; Prévost, D.; Brar, S.K.; Pouleur, S.; Surampalli, R.Y. Mycoparasitic Trichoderma Viride as a Biocontrol Agent against Fusarium Oxysporum f. Sp. Adzuki and Pythium Arrhenomanes and as a Growth Promoter of Soybean. Crop Prot. 2010, 29, 1452–1459. [Google Scholar] [CrossRef]
- Krauss, U.; Bidwell, R.; Ince, J. Isolation and Preliminary Evaluation of Mycoparasites as Biocontrol Agents of Crown Rot of Banana. Biol. Control 1998, 13, 111–119. [Google Scholar] [CrossRef]
- Hibar, K.; Daami-Remadi, M.; Khiareddine, H.; El Mahjoub, M. Effet Inhibiteur in Vitro et in Vivo Du Trichoderma Harzianum Sur Fusarium Oxysporum f. Sp. Radicis-Lycopersici. BASE 2005, 9, 163–171. [Google Scholar]
- Tondje, P.R.; Roberts, D.P.; Bon, M.C.; Widmer, T.; Samuels, G.J.; Ismaiel, A.; Begoude, A.D.; Tchana, T.; Nyemb-Tshomb, E.; Ndoumbe-Nkeng, M. Isolation and Identification of Mycoparasitic Isolates of Trichoderma Asperellum with Potential for Suppression of Black Pod Disease of Cacao in Cameroon. Biol. Control 2007, 43, 202–212. [Google Scholar] [CrossRef]
- Calistru, C.; McLean, M.; Berjak, P. In Vitro Studies on the Potential for Biological Control of Aspergillus Flavus and Fusarium Moniliforme by Trichoderma Species. Mycopathologia 1997, 137, 115–124. [Google Scholar] [CrossRef]
- Collins, R.P.; Halim, A.F. Characterization of the Major Aroma Constituent of the Fungus Trichoderma Viride. J. Agric. Food Chem. 1972, 20, 437–438. [Google Scholar] [CrossRef]
- Claydon, N.; Allan, M.; Hanson, J.R.; Avent, A.G. Antifungal Alkyl Pyrones of Trichoderma Harzianum. Trans. Br. Mycol. Soc. 1987, 88, 503–513. [Google Scholar] [CrossRef]
- Bonnarme, P.; Djian, A.; Latrasse, A.; Féron, G.; Ginies, C.; Durand, A.; Le Quéré, J.-L. Production of 6-Pentyl-α-Pyrone by Trichoderma Sp. from Vegetable Oils. J. Biotechnol. 1997, 56, 143–150. [Google Scholar] [CrossRef]
- Reithner, B.; Brunner, K.; Schuhmacher, R.; Peissl, I.; Seidl, V.; Krska, R.; Zeilinger, S. The G Protein α Subunit Tga1 of Trichoderma Atroviride Is Involved in Chitinase Formation and Differential Production of Antifungal Metabolites. Fungal Genet. Biol. 2005, 42, 749–760. [Google Scholar] [CrossRef]
- Reithner, B.; Schuhmacher, R.; Stoppacher, N.; Pucher, M.; Brunner, K.; Zeilinger, S. Signaling via the Trichoderma Atroviride Mitogen-Activated Protein Kinase Tmk1 Differentially Affects Mycoparasitism and Plant Protection. Fungal Genet. Biol. 2007, 44, 1123–1133. [Google Scholar] [CrossRef] [PubMed]
- Cooney, J.M.; Lauren, D.R.; di Menna, M.E. Impact of Competitive Fungi on Trichothecene Production by Fusarium Graminearum. J. Agric. Food Chem. 2001, 49, 522–526. [Google Scholar] [CrossRef]
- El-Hasan, A.; Walker, F.; Schöne, J.; Buchenauer, H. Antagonistic Effect of 6-Pentyl-Alpha-Pyrone Produced by Trichoderma Harzianum toward Fusarium Moniliforme. J. Plant Dis. Prot. 2007, 114, 62–68. [Google Scholar] [CrossRef]
- Scarselletti, R.; Faull, J.L. In Vitro Activity of 6-Pentyl-α-Pyrone, a Metabolite of Trichoderma Harzianum, in the Inhibition of Rhizoctonia Solani and Fusarium Oxysporum f. Sp. Lycopersici. Mycol. Res. 1994, 98, 1207–1209. [Google Scholar] [CrossRef]
- Vinale, F.; Sivasithamparam, K.; Ghisalberti, E.L.; Marra, R.; Barbetti, M.J.; Li, H.; Woo, S.L.; Lorito, M. A Novel Role for Trichoderma Secondary Metabolites in the Interactions with Plants. Physiol. Mol. Plant Pathol. 2008, 72, 80–86. [Google Scholar] [CrossRef]
- Rosales, E.; Pazos, M.; Sanromán, M.Á. Solid-State Fermentation for Food Applications. In Current Developments in Biotechnology and Bioengineering; Elsevier: Amsterdam, The Netherland, 2018; pp. 319–355. [Google Scholar]
- Hashim, P.; Selamat, J.; Syed Muhammad, S.K.; Ali, A. Effect of Mass and Turning Time on Free Amino Acid, Peptide-N, Sugar and Pyrazine Concentration during Cocoa Fermentation. J. Sci. Food Agric. 1998, 78, 543–550. [Google Scholar] [CrossRef]
- Besson, I.; Creuly, C.; Gros, J.B.; Larroche, C. Pyrazine Production by Bacillus Subtilis in Solid-State Fermentation on Soybeans. Appl. Microbiol. Biotechnol. 1997, 47, 489–495. [Google Scholar] [CrossRef]
- Gu, Y.-Q.; Mo, M.-H.; Zhou, J.-P.; Zou, C.-S.; Zhang, K.-Q. Evaluation and Identification of Potential Organic Nematicidal Volatiles from Soil Bacteria. Soil Biol. Biochem. 2007, 39, 2567–2575. [Google Scholar] [CrossRef]
- Chen, H.; Xiao, X.; Wang, J.; Wu, L.; Zheng, Z.; Yu, Z. Antagonistic Effects of Volatiles Generated by Bacillus Subtilis on Spore Germination and Hyphal Growth of the Plant Pathogen, Botrytis Cinerea. Biotechnol. Lett. 2008, 30, 919–923. [Google Scholar] [CrossRef]
- Chaves-López, C.; Serio, A.; Gianotti, A.; Sacchetti, G.; Ndagijimana, M.; Ciccarone, C.; Stellarini, A.; Corsetti, A.; Paparella, A. Diversity of Food-Borne Bacillus Volatile Compounds and Influence on Fungal Growth. J. Appl. Microbiol. 2015, 119, 487–499. [Google Scholar] [CrossRef]
- Xuan, Q.-C.; Huang, R.; Miao, C.-P.; Chen, Y.-W.; Zhai, Y.-Z.; Song, F.; Wang, T.; Wu, S.-H. Secondary Metabolites of Endophytic Fungus Trichoderma Sp. Ym 311505 of Azadirachta Indica. Chem. Nat. Compd. 2014, 50, 139–141. [Google Scholar] [CrossRef]
- Li, M.-F.; Li, G.-H.; Zhang, K.-Q. Non-Volatile Metabolites from Trichoderma Spp. Metabolites 2019, 9, 58. [Google Scholar] [CrossRef]
- Ahluwalia, V.; Kumar, J.; Rana, V.S.; Sati, O.P.; Walia, S. Comparative Evaluation of Two Trichoderma Harzianum Strains for Major Secondary Metabolite Production and Antifungal Activity. Nat. Prod. Res. 2015, 29, 914–920. [Google Scholar] [CrossRef]
- Chantrapromma, S.; Jeerapong, C.; Phupong, W.; Quah, C.K.; Fun, H.-K. Trichodermaerin: A Diterpene Lactone from Trichoderma Asperellum. Acta Crystallogr. Sect. E Struct. Rep. Online 2014, 70, o408–o409. [Google Scholar] [CrossRef]
- Chen, L.; Zhong, P.; Pan, J.-R. Asperelines G and H, Two New Peptaibols from the Marine-Derived Fungus Trichoderma Asperellum. Heterocycles Int. J. Rev. Commun. Heterocycl. Chem. 2013, 87, 645–655. [Google Scholar] [CrossRef]
- Song, Y.-P.; Miao, F.-P.; Fang, S.-T.; Yin, X.-L.; Ji, N.-Y. Halogenated and Nonhalogenated Metabolites from the Marine-Alga-Endophytic Fungus Trichoderma Asperellum Cf44-2. Mar. Drugs 2018, 16, 266. [Google Scholar] [CrossRef]
- Zhou, P.; Wu, Z.; Tan, D.; Yang, J.; Zhou, Q.; Zeng, F.; Zhang, M.; Bie, Q.; Chen, C.; Xue, Y. Atrichodermones A–C, Three New Secondary Metabolites from the Solid Culture of an Endophytic Fungal Strain, Trichoderma Atroviride. Fitoterapia 2017, 123, 18–22. [Google Scholar] [CrossRef] [PubMed]
- McMullin, D.R.; Renaud, J.B.; Barasubiye, T.; Sumarah, M.W.; Miller, J.D. Metabolites of Trichoderma Species Isolated from Damp Building Materials. Can. J. Microbiol. 2017, 63, 621–632. [Google Scholar] [CrossRef]

| Strains | * EtOAc Extracts of | |||||||||||
|---|---|---|---|---|---|---|---|---|---|---|---|---|
| T. asperellum | T. atroviride | |||||||||||
| Concentrations mg/mL | 0 | 1 | 10 | 25 | 50 | 100 | 0 | 1 | 10 | 25 | 50 | 100 |
| Penicillium digitatum | - | - | + | ++ | +++ | +++ | - | - | + | ++ | ++ | ++ |
| Penicillium commune | - | - | + | +++ | +++ | +++ | - | - | + | + | ++ | ++ |
| Penicillium expansum | - | + | ++ | ++ | +++ | +++ | - | - | + | ++ | ++ | ++ |
| Penicillium roqueforti | - | - | + | ++ | ++ | ++++ | - | - | + | + | + | ++ |
| Penicillium camemberti | - | ++ | ++ | +++ | ++++ | +++++ | - | - | + | + | ++ | ++ |
| Penicillium brevicopactum | - | - | + | ++ | +++ | ++++ | - | - | + | + | + | ++ |
| Penicillium verrucosum | - | - | ++ | ++ | ++ | +++ | - | - | + | + | + | ++ |
| Aspergillus parasiticus | - | - | + | + | +++ | ++++ | - | - | - | - | + | ++ |
| Aspergillus flavus | - | - | ++ | ++ | ++ | ++++ | - | - | + | + | ++ | ++ |
| Aspergillus niger | - | + | + | ++++ | ++++ | +++++ | - | - | + | + | ++ | ++ |
| Aspergillus steynii | - | ++ | +++ | +++++ | +++++ | +++++ | - | - | + | ++ | ++ | ++ |
| Aspergillus carbonarius | - | + | + | +++ | +++++ | ++++ | - | - | + | + | + | ++ |
| Aspergillus lacticoffeatus | - | - | ++ | +++ | ++++ | +++++ | - | - | + | + | ++ | ++ |
| Fusarium proliferatum | - | - | ++ | ++ | +++ | +++ | - | - | + | + | ++ | ++ |
| Fusarium verticillioides | - | - | + | ++ | +++ | ++++ | - | - | - | + | ++ | ++ |
| Fusarium sporotrichoides | - | - | ++ | ++ | +++ | ++++ | - | - | + | + | + | ++ |
| Fusarium langsethiae | - | - | + | + | ++ | +++ | - | - | - | + | ++ | ++ |
| Fusarium poae | - | - | ++ | ++ | ++ | +++ | - | - | + | + | ++ | ++ |
| Fusarium graminearum | - | - | + | ++ | +++ | ++++ | - | - | - | + | ++ | ++ |
| Neofusicoccum batangarum | - | - | + | +++ | +++++ | +++++ | - | - | + | +++ | ++++ | +++++ |
| Neofusicoccum parvum | - | - | + | +++ | +++++ | +++++ | - | - | + | +++ | ++++ | +++++ |
| Colletotrichum acutatum | - | - | + | ++ | +++ | +++ | - | - | + | + | ++ | +++ |
| Colletotrichum gloeosporioides | - | - | + | + | +++ | +++++ | - | - | - | + | ++ | +++ |
| Phytophthora parvispora | - | - | ++ | +++ | ++++ | +++++ | - | - | + | ++ | ++ | ++++ |
| Phytophthora nicotianae | - | - | ++ | +++ | ++++ | +++++ | - | - | ++ | ++++ | +++ | +++++ |
| Strains | EtOAc Extract of | |||
|---|---|---|---|---|
| T. asperellum | T. atroviride | |||
| MIC | MFC | MIC | MFC | |
| Neofusicoccum batangarum | 0.39 | 0.78 | 3.13 | 3.13 |
| Neofusicoccum parvum | 0.78 | 0.78 | 3.13 | 6.25 |
| Colletotrichum acutatum | 0.39 | 1.56 | 1.56 | 3.13 |
| Colletotrichum gloeosporioides | 0.39 | 1.56 | 1.56 | 3.13 |
| Phytophthora parvispora | 0.39 | 0.78 | 1.56 | 3.13 |
| Phytophthora nicotianae | 0.19 | 0.78 | 1.56 | 3.13 |
| Penicillium digitatum | 0.09 | 0.39 | 0.19 | 0.39 |
| Penicillium commune | 0.09 | 0.39 | 0.19 | 0.39 |
| Penicillium expansum | 0.09 | 0.39 | 0.19 | 0.78 |
| Penicillium roqueforti | 0.09 | 0.39 | 0.19 | 0.39 |
| Penicillium camemberti | 0.19 | 0.78 | 0.39 | 0.78 |
| Penicillium brevicopactum | 0.09 | 0.39 | 0.19 | 0.78 |
| Penicillium verrucosum | 0.39 | 0.78 | 1.56 | 1.56 |
| Aspergillus parasiticus | 0.39 | 0.78 | 3.13 | 6.25 |
| Aspergillus flavus | 0.39 | 0.78 | 3,13 | 6.25 |
| Aspergillus niger | 0.39 | 0.78 | 1.56 | 3.13 |
| Aspergillus steynii | 0.09 | 0.19 | 0.78 | 1.56 |
| Aspergillus carbonarius | 0.39 | 0.78 | 1.56 | 3.13 |
| Aspergillus lacticoffeatus | 0.39 | 0.78 | 3.13 | 3.13 |
| Fusarium proliferatum | 0.39 | 0.78 | 0.78 | 0.78 |
| Fusarium verticillioides | 0.78 | 0.78 | 0.78 | 1.56 |
| Fusarium sporotrichoides | 0.19 | 0.78 | 0.19 | 0.78 |
| Fusarium langsethiae | 0.39 | 1.56 | 0.78 | 1.56 |
| Fusarium poae | 0.39 | 0.78 | 0.78 | 0.78 |
| Fusarium graminearum | 0.39 | 0.78 | 0.78 | 1.56 |
| Strains | Trichoderma asperellum | Trichoderma atroviride | ||||
|---|---|---|---|---|---|---|
| First Day | Third Day | Seventh Day | First Day | Third Day | Seventh Day | |
| Neofusicoccum batangarum | 3.64 ± 1.82 | 37.78 ± 2.00 | 63.75 ± 2.6 * | 14.55 ± 3.64 | 36.67 ± 1.67 | 67.50 ± 1.44 * |
| Neofusicoccum parvum | 6.45 ± 3.23 | 43.75 ± 0.83 | 54.17 ± 0.42 * | 8.06 ± 2.79 | 41.35 ± 0.48 | 63.33 ± 2.32 * |
| Colletotrichum acutatum | ND a | 3.17 ± 1.59 | 46.28 ± 2.19 | ND | ND | 47.93 ± 1.43 |
| Colletotrichum gloeosporioides | ND | 10.26 ± 1.28 | 59.01 ± 0 * | 13.33 ± 3.33 | 14.10 ± 1.28 | 58.39 ± 2.24 |
| Phytophthora parvispora | ND | 9.09 ± 0 | 48.62 ± 0.92 * | ND | 9.09 ± 0 | 44.95 ± 0 |
| Phytophthora nicotianae | 5.77 ± 1.92 | 22.39 ± 1.49 | 76.24 ± 2.97 * | 7.69 ± 0 | 25.37 ± 1.49 | 81.19 ± 0.99 * |
| Penicillium digitatum | ND | 3.03 ± 1.52 | 56.52 ± 1.26 * | ND | ND | 71.01 ± 2.61 * |
| Penicillium commune | ND | 20.00 ± 4.00 | 51.85 ± 1.85 | ND | 12.00 ± 4.00 | 68.52 ± 1.85 * |
| Penicillium expansum | ND | ND | 18.18 ± 3.15 | ND | ND | 30.91 ± 7.93 |
| Penicillium roqueforti | ND | ND | 51.67 ± 0.83 * | ND | 7.02 ± 1.75 | 75.83 ± 6.01 * |
| Penicillium camemberti | ND | ND | 25.71 ± 12.45 | ND | 9.09 ± 4.55 | 28.57 ± 10.30 |
| Penicillium brevicopactum | ND | 11.11 ± 5.56 | 43.90 ± 2.44 | ND | 22.22 ± 14.70 | 68.29 ± 4.88 |
| Penicillium verrucosum | ND | 15.79 ± 5.26 | 42.42 ± 6.06 * | ND | 21.05 ± 9.12 | 63.64 ± 5.25 * |
| Aspergillus parasiticus | 2.70 ± 0 | 4.82 ± 1.20 | 46.05 ± 0.66 | 13.51 ± 2.70 | 16.87 ± 7.23 | 50.00 ± 7.59 |
| Aspergillus flavus | ND | 4.11 ± 1.37 | 38.52 ± 0 | ND | 4.11 ± 2.74 | 22.95 ± 3.57 |
| Aspergillus niger | ND | 8.99 ± 1.95 | 45.86 ± 1.69 | ND | ND | 41.40 ± 3.87 |
| Aspergillus steynii | ND | ND | 42.22 ± 1.11 | ND | ND | 25.56 ± 1.11 * |
| Aspergillus carbonarius | ND | 6.82 ± 1.14 | 40.58 ± 0.72 | ND | ND | 23.91 ± 2.17 |
| Aspergillus lacticoffeatus | ND | 4.11 ± 2.74 | 34.55 ± 1.57 | 8.11 ± 2.70 | 9.59 ± 4.11 | 21.82 ± 0.91 |
| Fusarium proliferatum | ND | 10.94 ± 2.71 | 50 ± 0.96 * | ND | 6.25 ± 0 | 42.31 ± 1.67 * |
| Fusarium verticillioides | 7.69 ± 0 | 9.59 ± 0 | 45.83 ± 3.00 | 7.69 ± 0 | 8.22 ± 1.37 | 35.83 ± 1.67 * |
| Fusarium sporotrichoides | ND | 5.88 ± 3.11 | 50 ± 2.47 * | ND | 3.53 ± 1.18 | 39.73 ± 1.37 * |
| Fusarium langsethiae | ND | 1.67 ± 1.67 | 42.57 ± 0.99 * | ND | 3.33 ± 1.67 | 30.69 ± 5.51 |
| Fusarium poae | ND | 12.82 ± 5.13 | 67.15 ± 2.53 * | ND | 2.56 ± 1.28 | 48.91 ± 1.93 * |
| Fusarium graminearum | ND | 3.03 ± 3.03 | 61.19 ± 5.22 * | ND | 6.06 ± 1.52 | 51.49 ± 1.97 |
| Compound (VOCs) | Strains | |
|---|---|---|
| Trichoderma asperellum | Trichoderma atroviride | |
| Alcohols | ||
| Ethanol | 0.58 ± 0.01 | 1.02 ± 0.07 |
| 2-methyl-1-propanol | 0.70 ± 0.01 | 0.68 ± 0.05 |
| 3-methyl-1-butanol | 4.47 ± 0.13 | 5.29 ± 0.23 |
| 3-methyl acetate-1-butanol | 0.35 ± 0.01 | ND |
| 2-methyl acetate-1-butanol | 0.18 ± 0.01 | ND |
| Benzyl alcohol | 0.35 ± 0.05 | ND |
| Phenylethyl Alcohol | 19.06 ± 0.08 | ND |
| 1-phenyl-2-propanol | ND * | 0.15 ± 0 |
| 2-(4-methoxyphenyl)ethanol | 0.71 ± 0.03 | ND |
| Aldehydes | ||
| Benzaldehyde | 0.13 ± 0 | 0.20 ± 0 |
| Benzeneacetaldehyde | 0.06 ± 0 | 0.91 ± 0.04 |
| 3-methyl-benzaldehyde | 0.30 ± 0.01 | ND |
| Nonanal | ND | 0.11 ± 0 |
| Acids | ||
| 1-methyl-6-oxopyridine-3-carboxylic acid | ND | 0.20 ± 0.01 |
| Ketones | ||
| 2,3-butandione | ND | 1.25 ± 0.04 |
| 3-ethyl-2-cyclopenten-1-one | 0.41 ± 0.03 | 0.87 ± 0.08 |
| Phenylacetone | ND | 0.23 ± 0.02 |
| 5,6,6-trimethyl-3,4-undecadiene-2,10-dione | 0.27 ± 0.02 | 1.55 ± 0.02 |
| Pyrazines | ||
| Trimethyl pyrazine | 0.09 ± 0.01 | 0.43 ± 0.03 |
| Tetramethyl pyrazine | 4.81 ± 0.04 | 56.79 ± 0.29 |
| 2,3,5-trimethyl-6-ethylpyrazine | 0.45 ± 0.01 | 1 ± 0.06 |
| 2,3,5-trimethyl-6-propylpyrazine | 0.14 ± 0 | 0.14 ± 0.01 |
| 2-methyl-3,5-diethylpyrazine | ND | 0.74 ± 0.02 |
| Trimethylisobutylpyrazine | ND | 0.86 ± 0.07 |
| 2,3-dimethyl-5-(1-propenyl)pyrazine | 0.04 ± 0 | ND |
| Esters | ||
| Ethyl acetate | 0.62 ± 0.01 | 0.46 ± 0 |
| Ethyl isobutyrate | 0.15 ± 0.02 | ND |
| Isobutyl butanoate | 0.22 ± 0.01 | ND |
| Ethyl β-hydroxybutyrate | 0.11 ± 0.01 | 0.22 ± 0 |
| Isoamyl 2-methylpropanoate | 0.18 ± 0.01 | ND |
| Butyl isobutyrate | 0.10 ± 0 | ND |
| Ethyl 3-acetoxybutanoate | ND | 0.34 ± 0.01 |
| β-phenylethyl formate | 0.14 ± 0.01 | ND |
| Ethyl benzeneacetate | ND | 1.16 ± 0.09 |
| 2-phenethyl acetate | 1.15 ± 0.05 | ND |
| Pentanoic acid, oct-4-yl ester | ND | 0.66 ± 0.07 |
| Isobutyl phenylacetate | ND | 0.08 ± 0.01 |
| α-phenylethyl butyrate | 0.41 ± 0.01 | ND |
| Butyl adipate | ND | 0.26 ± 0.02 |
| Others | ||
| 2,2-diphenyl-2H-1-benzopyran | 0.22 ± 0.02 | ND |
| Trimethyloxazole | ND | 0.83 ± 0.03 |
| 2-pentyl furan | 0.19 ± 0.01 | ND |
| Methyl hydroxytriazaindolizine | 0.08 ± 0 | ND |
| 5,6,7,8-tetrahydro-2-methyl-4H-chromen-4-one | 0.23 ± 0.01 | 1.38 ± 0.08 |
| Methyl 3,4-di-O-acetyl-2-O-methylfucofuranoside | 0.16 ± 0.01 | ND |
| 1,3-di-tert-butylbenzene | 0.20 ± 0.02 | 0.48 ± 0.18 |
| 2,4-dimethyl-3-acetylpyrrole | ND | 0.29 ± 0.04 |
| 6,7-dimethyl-1,2,3,5,8,8a-hexahydronaphthalene | 0.22 ± 0.03 | ND |
| 3-methylhexyl isothiocyanate | ND | 1.39 ± 0.10 |
| 6-pentyl-alpha-pyrone | 42.66 ± 0.15 | 0.26 ± 0 |
| α-Himachalene | 2.14 ± 0.13 | 0.61 ± 0.01 |
| α-Zingiberene | 5.86 ± 0.01 | 2.67 ± 0.14 |
| 1-hydroxy-2,4-di-tert-butylbenzene | 2.50 ± 0.04 | 6.17 ± 0.04 |
| Butylated hydroxytoluene | 0.58 ± 0.01 | 1.66 ± 0.11 |
| α-Sesquiphellandrene | 6.60 ± 0.07 | 2.43 ± 0.05 |
| Nerolidol | ND | 0.86 ± 0.01 |
| Cedrene | 0.34 ± 0.08 | ND |
| 6,7-dihydro-2-trans-farnesol | 0.63 ± 0.04 | ND |
| 1,2,4,4,6-pentamethyl-1,4-dihydropyridine-3,5-dicarbonitrile | ND | 1.19 ± 0.01 |
| Ledol | 0.95 ± 0.02 | 3.04 ± 0.36 |
| Phenol, 2-(1,1-dimethylethyl)-4-(1-methyl-1-phenylethyl | 0.26 ± 0 | 1.15 ± 0.76 |
| Compound (nVOCs) | MW | Molecular Formula | m/z | Ion | RT | Days of Fermentation | Reference |
|---|---|---|---|---|---|---|---|
| Trichodermaerin | 316.20 | C20 H28 O3 | 317.2104 | [M+H]+ | 15.9 | 30 | [47] |
| Aspereline H | 978.62 | C47 H82 N10 O12 | 977.6099 | [M-H]− | 16.7 | 10 | [48] |
| Aspereline A | 936.60 | C45 H80 N10 O11 | 935.5956 | [M-H]− | 19.3 | 10 | [48] |
| Aspereline E | 952.60 | C45 H80 N10 O12 | 951.5935 | [M-H]− | 16.6 | 10 | [48] |
| Methylcordysinin A | 240.15 | C12 H20 N2 O3 | 299.1628 | [M+CH3COO]− | 20.7 | 10 | [49] |
| 3,5,9-trihydroxyergosta-7,22-dien- 6-one | 444.32 | C28 H44 O4 | 489.3224 | [M-HCOO]− | 9.4 | 30 | [44] |
| Ergosta-7,22-dien-3-ol | 398.36 | C28 H46 O | 397.3486 | [M-H]− | 30.3 | 10–30 | [45] |
| Beta-sitosterol | 414.39 | C29 H50 O | 413.3784 | [M-H]− | 33.3 | 10 | [47] |
| Adenine nucleoside | 267.10 | C10 H13 N5 O4 | 312.0953 | [M-HCOO]− | 5.5 | 30 | [45] |
| Atrichodermone B | 156.08 | C8 H12 O3 | 215.0914 | [M+CH3COO]− | 9.3 | 30 | [50] |
| Atrichodermone C | 236.18 | C15 H24 O2 | 295.1906 | [M+CH3COO]− | 23.5 | 30 | [50] |
| 6-pent-1-enyl-pyran-2-one | 164.08 | C10 H12 O2 | 165.0915 | [M+H]+ | 9.9 | 30 | [51] |
Publisher’s Note: MDPI stays neutral with regard to jurisdictional claims in published maps and institutional affiliations. |
© 2020 by the authors. Licensee MDPI, Basel, Switzerland. This article is an open access article distributed under the terms and conditions of the Creative Commons Attribution (CC BY) license (http://creativecommons.org/licenses/by/4.0/).
Share and Cite
Stracquadanio, C.; Quiles, J.M.; Meca, G.; Cacciola, S.O. Antifungal Activity of Bioactive Metabolites Produced by Trichoderma asperellum and Trichoderma atroviride in Liquid Medium. J. Fungi 2020, 6, 263. https://doi.org/10.3390/jof6040263
Stracquadanio C, Quiles JM, Meca G, Cacciola SO. Antifungal Activity of Bioactive Metabolites Produced by Trichoderma asperellum and Trichoderma atroviride in Liquid Medium. Journal of Fungi. 2020; 6(4):263. https://doi.org/10.3390/jof6040263
Chicago/Turabian StyleStracquadanio, Claudia, Juan Manuel Quiles, Giuseppe Meca, and Santa Olga Cacciola. 2020. "Antifungal Activity of Bioactive Metabolites Produced by Trichoderma asperellum and Trichoderma atroviride in Liquid Medium" Journal of Fungi 6, no. 4: 263. https://doi.org/10.3390/jof6040263
APA StyleStracquadanio, C., Quiles, J. M., Meca, G., & Cacciola, S. O. (2020). Antifungal Activity of Bioactive Metabolites Produced by Trichoderma asperellum and Trichoderma atroviride in Liquid Medium. Journal of Fungi, 6(4), 263. https://doi.org/10.3390/jof6040263

